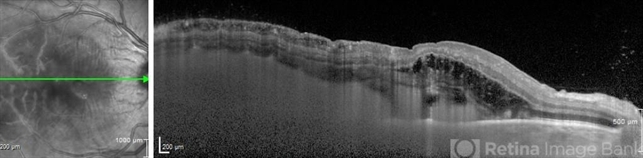

-
 By Eric J. Sigler, M.D.
By Eric J. Sigler, M.D.
NY Retina - Uploaded on Oct 15, 2012.
- Last modified by Eric J. Sigler, M.D. on Oct 16, 2012.
- Rating
- Appears in
- del-Endogenous Aspergillus Endophthalmitis
- Condition/keywords
- optical coherence tomography (OCT), enhanced depth imaging, endogenous endophthalmitis
- Photographer
- Byron Wood
- Imaging device
-
Optical coherence tomography system
Spectralis, Heidelberg Engineering, Heidelberg, Germany - Description
- Enhanced depth imaging spectral domain optical coherence tomography with corresponding scanning laser ophthalmoscopic image of endogenous Aspergillus endophthalmitis. SD-OCT imaging of posterior vitreous cells are demonstrated in the right-most portion of the image (peripapillary region).

Initializing download.
Initializing download.










